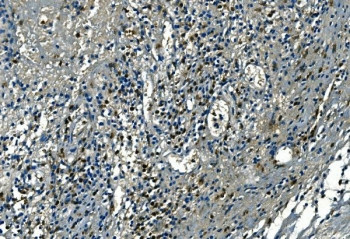
Anti-Azurocidin / AZU1 / CAP37

Cookie preferences
This website uses cookies, which are necessary for the technical operation of the website and are always set. Other cookies, which increase the comfort when using this website, are used for direct advertising or to facilitate interaction with other websites and social networks, are only set with your consent.
Configuration
Technically required
These cookies are necessary for the basic functions of the shop.
"Allow all cookies" cookie
"Decline all cookies" cookie
CSRF token
Cookie preferences
Currency change
Customer-specific caching
FACT-Finder tracking
Individual prices
Selected shop
Session
Comfort functions
These cookies are used to make the shopping experience even more appealing, for example for the recognition of the visitor.
Note
Show the facebook fanpage in the right blod sidebar
Statistics & Tracking
Affiliate program
Conversion and usertracking via Google Tag Manager
Track device being used
| Item number | Size | Datasheet | Manual | SDS | Delivery time | Quantity | Price |
|---|---|---|---|---|---|---|---|
| NSJ-RQ6825 | 100 µg | - | - |
3 - 10 business days* |
790.00€
|
If you have any questions, please use our Contact Form.
You can also order by e-mail: info@biomol.com
Larger quantity required? Request bulk
You can also order by e-mail: info@biomol.com
Larger quantity required? Request bulk
0.5mg/ml if reconstituted with 0.2ml sterile DI water. Azurocidin also known as cationic... more
Product information "Anti-Azurocidin / AZU1 / CAP37"
0.5mg/ml if reconstituted with 0.2ml sterile DI water. Azurocidin also known as cationic antimicrobial protein CAP37 or heparin-binding protein (HBP) is a protein that in humans is encoded by the AZU1 gene. Azurophil granules, specialized lysosomes of the neutrophil, contain at least 10 proteins implicated in the killing of microorganisms. This gene encodes a preproprotein that is proteolytically processed to generate a mature azurophil granule antibiotic protein, with monocyte chemotactic and antimicrobial activity. It is also an important multifunctional inflammatory mediator. This encoded protein is a member of the serine protease gene family but it is not a serine proteinase, because the active site serine and histidine residues are replaced. The genes encoding this protein, neutrophil elastase 2, and proteinase 3 are in a cluster located at chromosome 19pter. All 3 genes are expressed coordinately and their protein products are packaged together into azurophil granules during neutrophil differentiation. Protein function: This is a neutrophil granule-derived antibacterial and monocyte- and fibroblast-specific chemotactic glycoprotein. Binds heparin. The cytotoxic action is limited to many species of Gram- negative bacteria, this specificity may be explained by a strong affinity of the very basic N-terminal half for the negatively charged lipopolysaccharides that are unique to the Gram-negative bacterial outer envelope. It may play a role in mediating recruitment of monocytes in the second wave of inflammation. Has antibacterial activity against the Gram-negative bacterium P.aeruginosa, this activity is inhibited by LPS from P.aeruginosa. Acting alone, it does not have antimicrobial activity against the Gram-negative bacteria A.actinomycetemcomitans ATCC 29532, A.actinomycetemcomitans NCTC 9709, A.actinomycetemcomitans FDC-Y4, H.aphrophilus ATCC 13252, E.corrodens ATCC 23834, C.sputigena ATCC 33123, Capnocytophaga sp ATCC 33124, Capnocytophaga sp ATCC 27872 or E.coli ML-35. Has antibacterial activity against C.sputigena ATCC 33123 when acting synergistically with either elastase or cathepsin G. [The UniProt Consortium]
| Keywords: | Anti-HBP, Anti-hHBP, Anti-Azurocidin, Anti-Heparin-binding protein, Anti-Cationic antimicrobial protein CAP37, Azurocidin Antibody / AZU1 / CAP37 |
| Supplier: | NSJ Bioreagents |
| Supplier-Nr: | RQ6825 |
Properties
| Application: | WB, IHC (paraffin), FC, Direct ELISA |
| Antibody Type: | Polyclonal |
| Conjugate: | No |
| Host: | Rabbit |
| Species reactivity: | human, mouse, rat |
| Immunogen: | Recombinant human protein (amino acids I27-N245) |
| Format: | Immune Reaction |
Database Information
| KEGG ID : | K24665 | Matching products |
| UniProt ID : | P20160 | Matching products |
| Gene ID : | GeneID 566 | Matching products |
Handling & Safety
| Storage: | +4°C |
| Shipping: | +4°C (International: +4°C) |
Caution
Our products are for laboratory research use only: Not for administration to humans!
Our products are for laboratory research use only: Not for administration to humans!
Information about the product reference will follow.
more
You will get a certificate here
Viewed